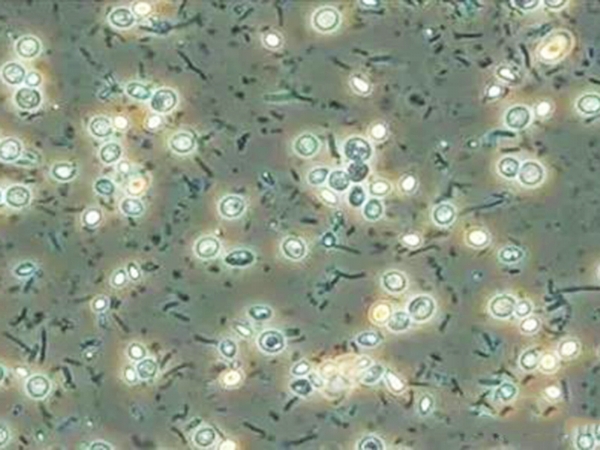
污水處理工藝選擇時要考慮的7個因素

new
污水處理工藝選擇時要考慮的7個因素
污水處理工藝選擇時要考慮的7個因素
污水處理流程的選擇應綜合考慮各項因素,進行多種方案的技術經濟比較才能得出結論,其中包括:廢水水質、污水處理程度、建設及運行費用、工程施工難易程度、當地的自然和社會條件、污水的水量和二次污染七個方面。
1、 廢水水質
生活污水水質通常比較穩定,一般的處理方法包括酸化、好氧生物處理、消毒等。而工業廢水應根據具體的水質情況進行工藝流程的合理選擇。特別需要指出的是,對于采用好氧生物處理工藝處理廢水來說,要注意廢水的可生化性,通常要求BOD5/COD>0.3,如不能滿足要求,可考慮進行厭氧生物水解酸化,以提高廢水的可生化性,或是考慮采用非生物處理的物理或化學方法等。
2、 污水處理程度
這是污水處理工藝流程選擇的主要依據。污水處理程度原則上取決于污水的水質特征、處理后水的去向和污水所流入水體的自凈能力。但是目前,污水處理程度的確定主要依從國家的有關法律制度及技術政策的要求。通常環境管理部門是根據《污水綜合排放標準》及相關的行業排放標準來控制污水的排放濃度,一些經濟發展水平較高的地區還規定了更為嚴格的地方排放標準。因此,無論是何種需要處理的污水,也無論是采取何種處理工藝及處理程度,都應以處理系統的出水能夠達標為依據和前提。按照法律、法規、政策的要求預防和治理水體環境污染。
3、 建設及運行費用
考慮建設與運行費用時,應以處理水達到水質標準為前提條件。在此前提下,工程建設及運行費用低的工藝流程應得到重視。此外,減少占地面積也是降低建設費用的重要措施。
4、 工程施工難易程度
工程施工的難易程度也是選擇工藝流程的影響因素之一。如地下水位高,地質條件差的地方,就不適宜選用深度大、施工難度高的處理構筑物。
5、 當地的自然和社會條件
當地的地形、氣候等自然條件也對廢水處理流程的選擇具有一定影響。如當地氣候寒冷,則應采用在采取適當的技術措施后,在低溫季節也能夠正常運行,并保證取得達標水質的工藝。
當地的社會條件如原材料、水資源與電力供應等也是流程選擇應當考慮的因素之一。
6、 污水的水量
除水質外,污水的水量也是影響因素之一。對于水量、水質變化大的污水,應首先考慮采用抗沖擊負荷能力強的工藝,或考慮設立調節池等緩沖設備以盡量減少不利影響。
7、 二次污染
污水處理過程中應注意是否會造成二次污染問題。例如制藥廠廢水中含有大量有機物質(如苯、甲苯、溴素等),在曝氣過程中會有有機廢氣排放,對周圍大氣環境造成影響;化肥廠造氣廢水在采用沉淀、冷卻處理后循環利用,在冷卻塔尾氣中會含有氰,對大氣造成污染;農藥廠樂果廢水處理中,以堿化法降解樂果,如采用石灰做堿化劑,產生的污泥會造成二次污染;印染或染料廠廢水處理時,污泥的處置為考慮的問題。
















 首頁
首頁
 產品
產品
 電話
電話